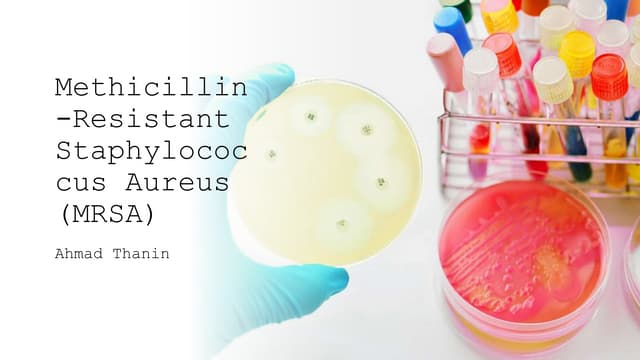
MRSA: Methicillin-Resistant Staphylococcus Aureus

| 내용 | 설명 |
| 명칭 | 메티실린 methicillin, INN |
| 계열 | 페니실린계 |
| 분류 | 항생제 |

내성균과의 싸움에서의 역할과 저항성
- 메티실린은 페니실린 계열의 항생제 중 하나
- 베타-락타메이스라는 효소로 인해 페니실린이 비효과적이 되는 것을 극복하기 위해 개발
메티실린의 진화
- 박테리아가 페니실린을 분해하는 메커니즘을 발전시키면서 과학자들은 베타-락타메이스에 저항할 수 있도록 메티실린의 화학 구조를 변화
- 메티실린이 처음에는 효과적이었지만 내성을 가진 MRSA(메티실린 내성 황색포도상구균)가 나타남
메티실린의 사용
- 메티실린은 주로 그람양성균 및 페니실린 내성 포도상구균과 같은 베타 락타아제를 생성하는 균을 치료하는 데 사용했음
- 현재 메티실린은 임상 현장에서는 더 이상 사용되지 않음
- 대신 플루클록사실린이나 디클록사실린 같은 다른 항생제가 사용됨
메티실린 내성균의 메커니즘
- MRSA 내성은 mecA 유전자의 획득으로 발생
- 이 유전자는 새로운 PBP(PBP2a)를 암호화함
- 이 내성 메커니즘은 센서 단백질 MecR1과 센서 단백질 억제자 MecI를 포함하는 단백질 분해 신호 전달 경로를 통해 조절
메티실린의 특징
- 메티실린은 위산에 의해 비활성화되므로 경구로는 투여할 수 없음
- 근육주사(IM 주사)나 정맥주사(IV 주사)가 필요
- 메티실린은 반감기가 20~60분으로 짧으며 주로 간에서 처리
- 메티실린은 세균의 세포벽 형성에 필수적인 페니실린 결합 단백질(PBP)에 결합하여 그 기능을 억제
- 이로 인해 세포벽 형성이 방해받아 박테리아가 사멸
- 메티실린은 한때 항생제 치료의 핵심이었으나 MRSA의 등장으로 그 사용이 감소
- 이는 항생제 개발과 박테리아 진화 사이의 지속적인 경쟁을 보여주는 사례
- 새로운 치료법 개발에 있어 항생제 작용 메커니즘과 저항 메커니즘 이해가 중요
'의료 > 어휘정리' 카테고리의 다른 글
| 타이레놀 - Tylenol 효능 및 효과 (0) | 2025.02.17 |
|---|---|
| 메티실린 내성 황색 포도상구균 - MRSA (Methicillin Resistant Staphylococcus Aureus) (3) | 2024.09.08 |
| 페니실린(Penicillin) (2) | 2024.09.06 |
| 향정신성약품 - 메틸페니데이트 (3) | 2024.09.03 |
| 의학용어 - 접두사2 (0) | 2023.09.22 |




댓글